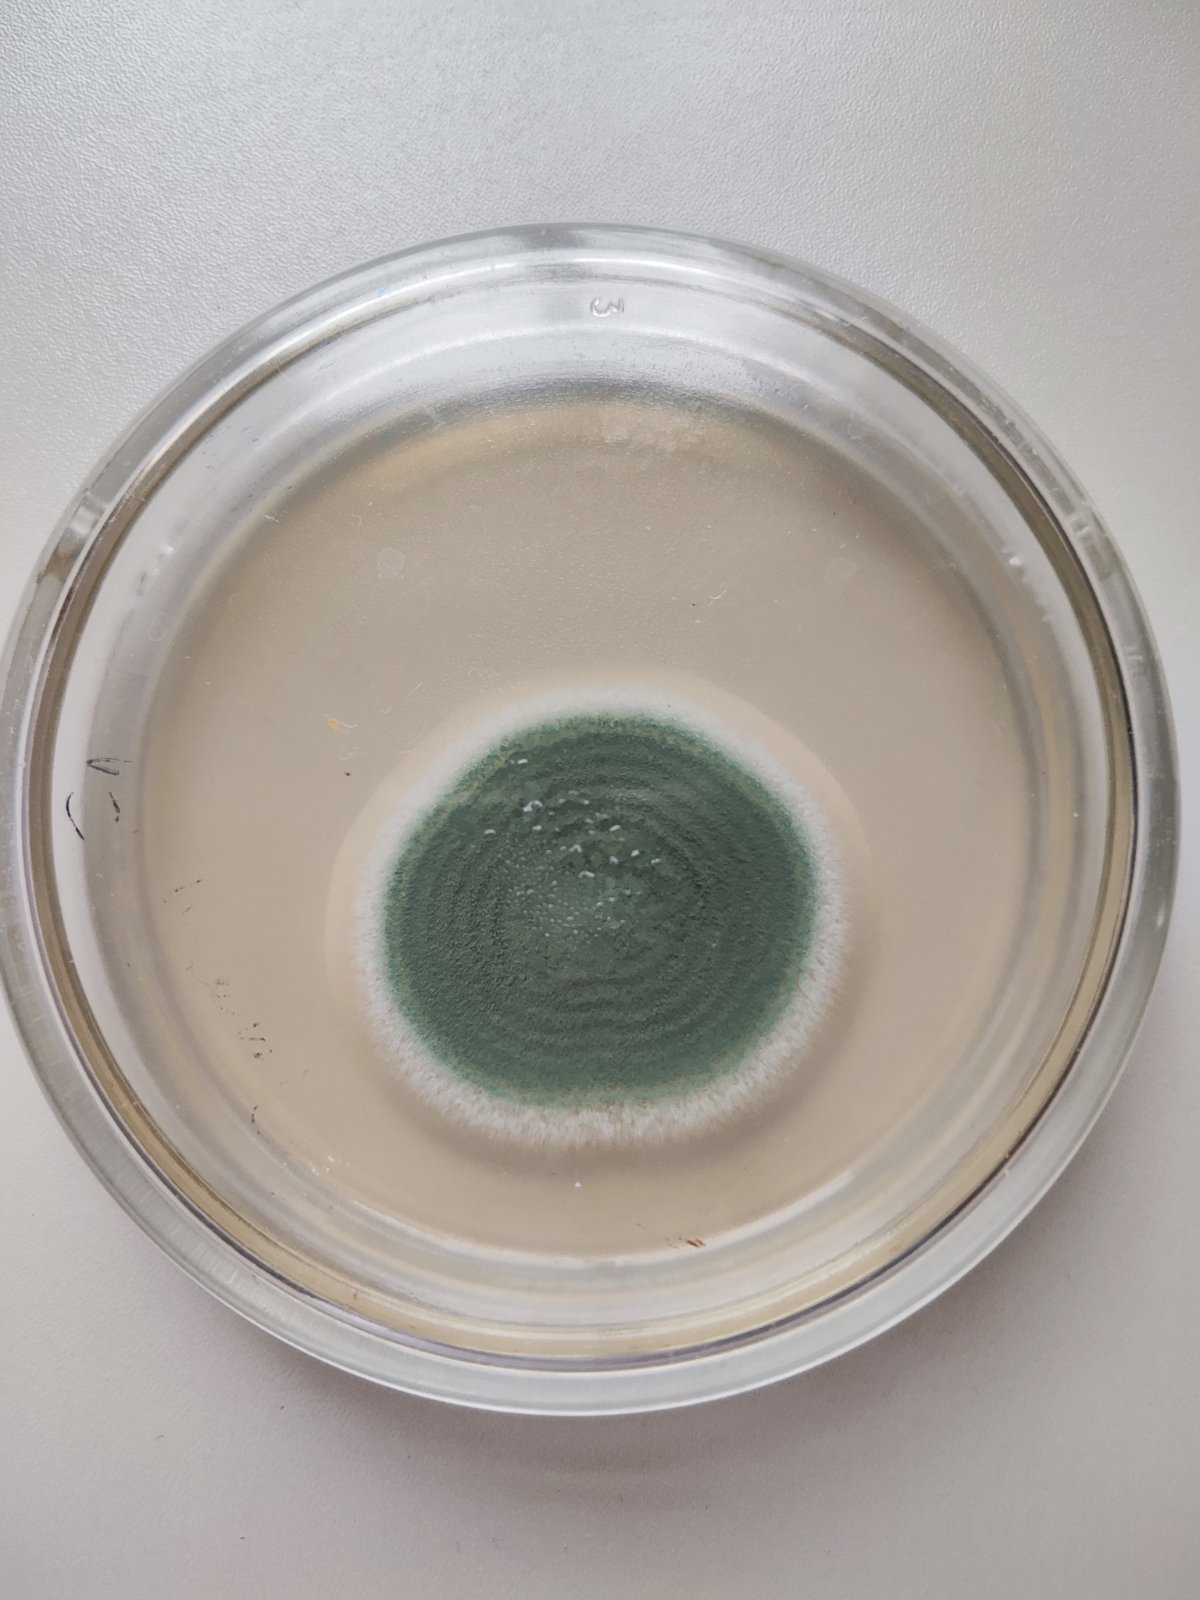

Практична підготовка
Створенно обєкти для практичного навчання на дослідному полі кафедри фітопатології ім. акад. В.Ф. Пересипкіна у ВП НУБіП України “Агрономічна дослідна станція”.
Два обєкти для практичного навчання - (1. Пшениця озима - 2,4 га., "Оцінка технічної ефективності протруйників насіння пшениці озимої. " 2. Кукурудза - 0,8 га "Випробування гібридів кукурудзи на стійкість до летючої сажки кукурудзи".





Колекція мікроміцетів — збудників хвороб сільськогосподарських культур та об’єктів навчального процесу
Створенно музей чистих культур грибів - збудників хвороб рослин (гриби родів Fusarium, Alternaria, Botrytis, Sclerotinium), продуцентів антибіотиків (гриби родів Trichoderma, Penicillium), збудників мікотоксикозів (гриби родів Fusarium, Aspergillus, Penicillium) для проведення лабораторних занять з дисциплін "Загальна мікологія", "Загальна фітопатологія", "Мікотоксикологія", "Антагоністичні мікроорганізми в захисті рослин". Регулярно проводиться виділення, ідентифікація та зберігання колекції грибів.
Колекція мікроміцетів включає ізоляти найбільш поширених та економічно важливих збудників хвороб сільськогосподарських культур. Зразки репрезентують ключові таксономічні групи фітопатогенних грибів та мікроміцетів, що застосовуються у навчальному процесі для поглибленого вивчення морфології, біології та патогенності грибів під час викладання дисциплін «Загальна мікологія», «Загальна фітопатологія», «Мікотоксикологія» та «Антагоністичні мікроорганізми в захисті рослин».
Колекція регулярно поповнюється й оновлюється шляхом виділення в чисту культуру, їх ідентифікації за морфологічними та молекулярними ознаками і підтриманням життєздатності штамів на поживних середовищах.
Колекція фітопатогенних мікроміцетів — збудників основних хвороб с.-г. культур:
1. Fusarium spp.
Таксономія: Ascomycota → Sordariomycetes → Hypocreales → Nectriaceae.
Представники роду Fusarium є одними з найпоширеніших фітопатогенів. У колекції наявні види, що викликають фузаріозні кореневі гнилі, фузаріозне в’янення овочевих і технічних культур (F. oxysporum), а також фузаріоз колоса зернових (F. graminearum, F. culmorum). Багато видів продукують мікотоксини (трихотецени, фумонізини), що робить їх важливими об’єктами дослідження в мікотоксикології.

2. Alternaria spp.
Таксономія: Ascomycota → Dothideomycetes → Pleosporales → Pleosporaceae.
Гриби роду Alternaria є типовими некротрофами, широко розповсюдженими на овочевих, технічних, плодових та олійних культурах. У колекції представлені види — збудники альтернаріозу томатів і картоплі (A. solani), хвороб капустяних (A. brassicae, A. brassicicola), соняшнику та моркви. Характерні темні булавоподібні конідії, здатні до продукування токсинів.

3. Botrytis spp.
Таксономія: Ascomycota → Leotiomycetes → Helotiales → Sclerotiniaceae.
Найбільш відомим представником є Botrytis cinerea — збудник сірої гнилі. Уражує овочеві, ягідні та декоративні культури, особливо за умов підвищеної вологості. У колекції доступні культури, що демонструють типову конідіальну стадію та утворення склероціїв, що важливо для вивчення циклу розвитку.

4. Sclerotinia spp.
Таксономія: Ascomycota → Leotiomycetes → Helotiales → Sclerotiniaceae.
У колекції наявні ізоляти Sclerotinia sclerotiorum — збудника білої склероціальної гнилі ріпаку, соняшнику, сої, овочів. Види здатні утворювати великі чорні склероції та апотеції, що робить їх важливими об’єктами для демонстрації сумчастої стадії.
5. Aspergillus spp.
Таксономія: Ascomycota → Eurotiomycetes → Eurotiales → Aspergillaceae.
Представлені культури з груп афлатоксиногенних видів (A. flavus, A. parasiticus), що є збудниками пліснявіння насіння, горіхів та кормів. Види мають значення як у фітопатології, так і в мікотоксикології.

6. Penicillium spp.
Таксономія: Ascomycota → Eurotiomycetes → Eurotiales → Aspergillaceae.
До колекції входять види, що викликають «зелені» та «сині» плісняви плодів, а також пліснявіння зернових і кормів(P. cyclopium P. patulum). Деякі види належать до продуцентів антибіотиків та утворюють мікотоксини (охратоксин, патулін).

Мікроміцети для навчальних цілей зі студентами
Колекція використовується для забезпечення лабораторних занять з дисциплін "Загальна мікологія" (лабораторні роботи №№ 1-4,8-26) та "Загальни фітопатологія" (лабораторні роботи №№ 1,8,12-21,27) та навчальна практика із "Загальної фітопатології" (тема №3). До навчальних об’єктів входять:
1. Моделі для вивчення морфології:
-
Aspergillus spp. — демонстрація конідіального спороношення;
-
Penicillium spp. —будова конідієносців;
-
Rhizopus, Mucor spp. — спорангіальне спороношення;
-
Alternaria spp. — будова конідієносців.
2. Для методик виділення та ідентифікації фітопатогенів
-
Fusarium spp. (структура макро- та мікроконідій);
-
Alternaria spp. (темні багатоклітинні конідії);
-
Botrytis spp. (склероції, конідіальне спороношення);
-
Sclerotinia spp. (склероції, конідіальне спороношення, творення апотеції).
3. Гриби — об’єкти біоконтролю
-
Trichoderma spp. (антагоністична активність проти Fusarium, Sclerotinia, Rhizoctonia).
Ці культури використовуються під час вивчення антагоністичної активності мікроміцетів.




Науково-методичне значення колекції
Колекція мікроміцетів використовується для:
-
вивчення морфологічних, культуральних та таксономічних ознак грибів;
-
опрацювання методів виділення фітопатогенів із рослинних тканин та ґрунту;
-
дослідження патогенності та токсиногенності грибів;
-
виконання курсових і магістерських робіт;
-
розробки методів біологічного контролю хвороб рослин.
Фітопатогенні мікроскопічні гриби, представлені в колекції, є важливими об’єктами як для фундаментальних мікологічних досліджень, так і для прикладних фітопатологічних задач, оскільки саме вони спричиняють значні втрати врожаю, погіршують якість продукції, впливають на екологічний стан агроценозів та є продуцентами мікотоксинів.
